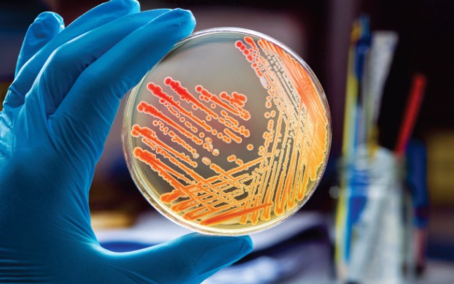

Высококачественная продукция для микробиологов различных специализаций. Все потребности удовлетворены! Titan Biotech (TM Media) Индия

Хорошая новость для микробиологов всех специализаций – предлагаем микробиологическую продукцию крупнейшего индийского производителя Titan Biotech (TM Media) с отличным ассортиментом и качеством.
Компания Titan Biotech Limited под торговой маркой TM media была основана в 1992 году с целью создания микробиологических продуктов оптимального качества. Работа началась с разработки основ биологических сред и отдельных ее компонентов, таких как пептоны.
После многолетней последовательной работы с использованием обширных исследований и передовых технологий в разработке питательных сред была создана линейка микробиологических продуктов, которые широко используются в области фармацевтики, нутрицевтики, продуктов питания и напитков, биотехнологии и ферментации, косметики, ветеринарии и кормов для животных сельского хозяйства, питательных сред для микробиологии и культур тканей растений.
Производство располагает контролируемыми чистыми помещениями и передовыми автоматическидми производственными установками, которые соответствуют строгим протоколам производства стерилизованных сред.
Ассортимент продукции Titan Biotech
Titan Biotech Ltd. имеет широкий ассортимент продукции, достигающий приблизительно 2500 наименований. Вся продукция сертифицированна по стандарту ISO 9001: 2008. В настоящее время Titan Biotech Limited отмечает свое присутствие в 77 странах по всему миру. Titan Biotech Limited является одним из самых узнаваемых брендов в странах Юго-Восточной Азии и Африки.
Titan Biotech Ltd. имеет широкий ассортимент продукции, достигающий приблизительно 2500 наименований. Вся продукция сертифицированна по стандарту ISO 9001: 2008.
В каталоге Titan Biotech широко представлена продукция для производственного санитарного-микробиологического контроля:
- основы биологических сред;
- сухие питательные среды;
- хромогенные среды;
- контактные чашки Петри;
- готовые чашки с агаром;
- добавки к питательным средам;
- диски с антибиотиками;
- оборудования для контроля воздуха (импакторы и воздухозаборники);
- оборудование для контроля жидкостей (фильтрационная установка).
Информация для заказа:
- На складе
- В транзите и на складе
- Все товары
|
TMH 111.500 gm
|
|
|
8 105
8 105 AMD
|
|
|
||||||
|
TM 544.500 gm
|
|
|
32 772
32 772 AMD
|
|
|
||||||
|
TMH 104.500 gm
|
|
|
37 186
37 186 AMD
|
|
|
||||||
|
TMH 108.500 gm
|
|
|
6 987
6 987 AMD
|
|
|
||||||
|
TME 004
|
|
|
По запросу По запросу |
|
|
||||||
|
TMPH 023
|
|
|
По запросу По запросу |
|
|
||||||
|
TM 986.500 gm
|
|
|
По запросу По запросу |
|
|
||||||
|
TMC 070
|
|
|
562 212
562 212 AMD
|
|
|
||||||
|
TSP 061GT
|
|
|
По запросу По запросу |
|
|
||||||
|
TM 1200.100 gm
|
|
|
хранение +2...+8°C
|
15 186
15 186 AMD
|
|
|
|||||
|
TMP 007GT
|
|
|
По запросу По запросу |
|
|
||||||
|
TMPH 015T
|
|
|
По запросу По запросу |
|
|
||||||
|
TMP 040
|
|
|
По запросу По запросу |
|
|
||||||
|
TMP 041GT
|
|
|
По запросу По запросу |
|
|
||||||
|
TMP 032GT
|
|
|
По запросу По запросу |
|
|
||||||
|
TMPH 021
|
|
|
По запросу По запросу |
|
|
||||||
|
TMPH 021T
|
|
|
По запросу По запросу |
|
|
||||||
|
TMP 012G
|
|
|
По запросу По запросу |
|
|
||||||
|
TMP 012GT
|
|
|
По запросу По запросу |
|
|
||||||
|
TMP 013
|
|
|
По запросу По запросу |
|
|
||||||
|
TMP 070GT
|
|
|
По запросу По запросу |
|
|
||||||
|
TSP 001GT
|
|
|
По запросу По запросу |
|
|
||||||
|
TMP 002GT
|
|
|
По запросу По запросу |
|
|
||||||
|
TMPH 024
|
|
|
По запросу По запросу |
|
|
||||||
|
|
|||||||||||
См. также:
Автоклавы (стерилизаторы паровые)
Боксы (шкафы) биологической безопасности
Гомогенизаторы лопаточные ("стомакер")
Пакеты для гомогенизации образцов
Счетчики колоний микроорганизмов
Термостаты (инкубаторы) нагревающие
Ссылка компании: Titan Biotech (TM Media)
Ниже вы можете задать вопрос или оставить запрос в свободной форме:
Все поля со звездочкой (*) обязательны для заполнения

Данное действие необратимо.
в ближайшее время.
чтобы сделать работу на сайте еще удобнее!
С помощью личного кабинета Вы сможете:
- моментально получать счета на оформленные заказы;
- отслеживать статусы выполнения заказа по оплате, отгрузке, наличию товаров на складе;
- вести историю заказов, повторять заказы полностью или частично;
- выбирать персонального менеджера;
- формировать списки избранного среди товаров, справочных материалов и видео;
- делать заказ со страницы избранных товаров;
- экономить время при заполнении форм заказа по каталогам и регистрации на мероприятия.























